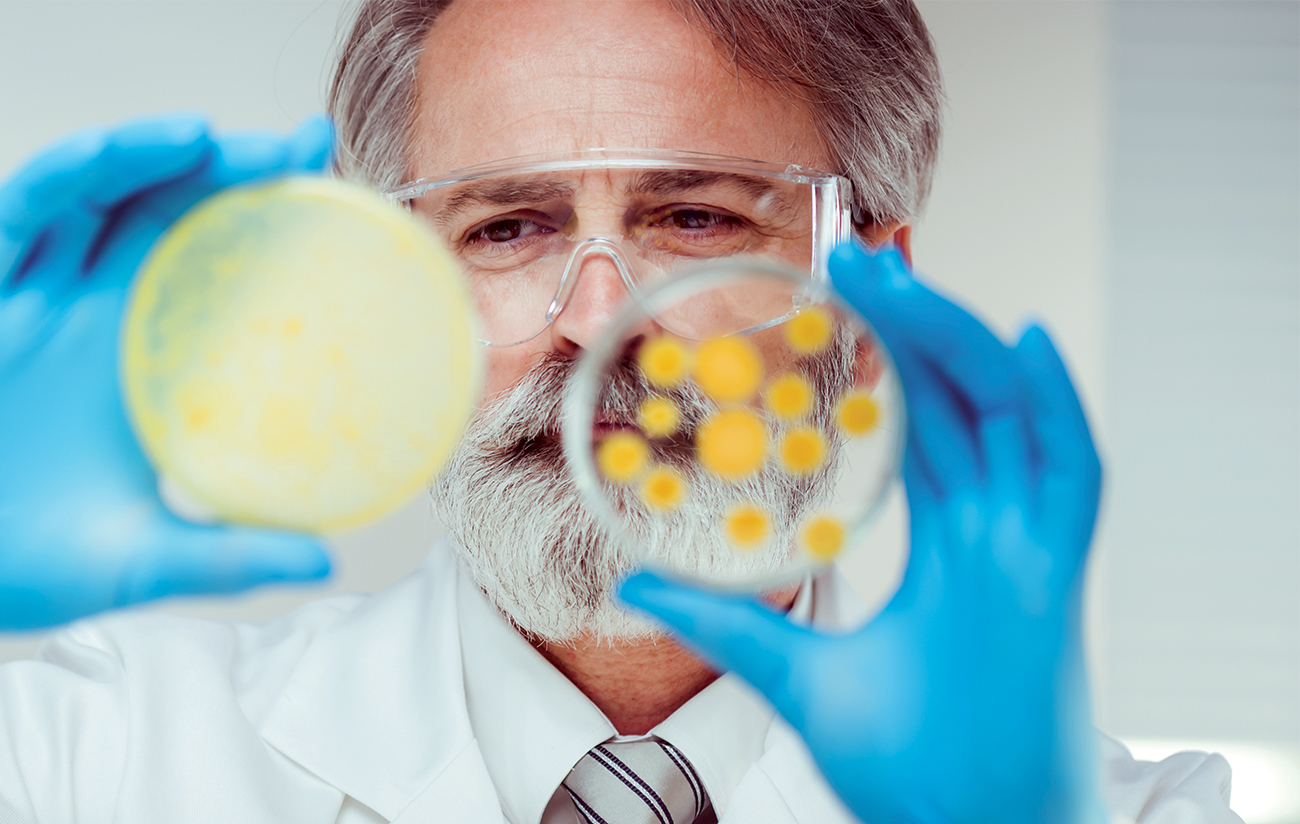

CRA is proud to support the New England region of the LLS Man & Woman of the year campaign, a philanthropic competition to support blood cancer research.
For more information on this cause, click here.
This website will offer limited functionality in this browser. We only support the recent versions of major browsers like Chrome, Firefox, Safari, and Edge.
CRA is proud to support the New England region of the LLS Man & Woman of the year campaign, a philanthropic competition to support blood cancer research.
For more information on this cause, click here.
From these sessions, CRA’s Aaron Everitt highlighted that while there are still relevant data releases and findings on existing immune checkpoint inhibitors,...
CRA’s Becky Davis examines how these dramatic price reductions, combined with Direct-to-Patient distribution models, may be accelerating employer migration...
Greg Bell is a panelist during the session titled “Navigating Life Sciences disputes. An arbitrator’s perspective.” For more information on this event, click...
CRA is a proud sponsor of the event covering divisional patent strategies, denigration, Article 102, enforcement, mergers, distribution, as well as...